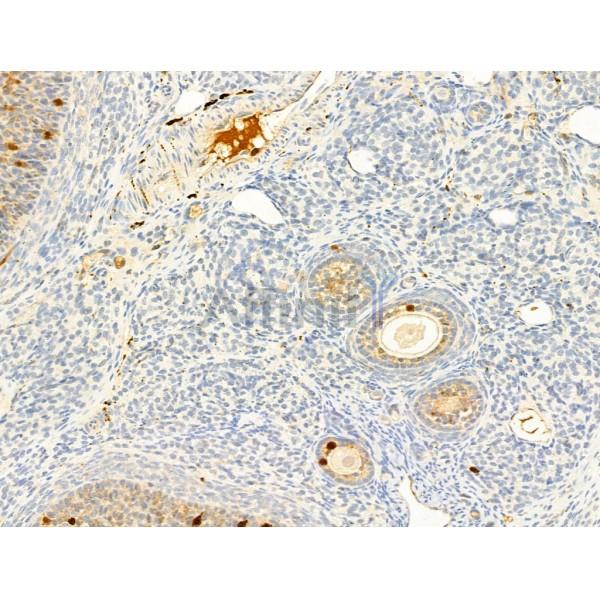
Phospho-ROCK2 (Tyr722) Antibody - AF3028 at 1/100 staining Rat ovary tissue by IHC-P.

Phospho-ROCK2 (Tyr722) Antibody - #AF3028
| Product: | Phospho-ROCK2 (Tyr722) Antibody |
| Catalog: | AF3028 |
| Description: | Rabbit polyclonal antibody to Phospho-ROCK2 (Tyr722) |
| Application: | WB IHC |
| Cited expt.: | WB |
| Reactivity: | Human, Mouse, Rat |
| Prediction: | Pig, Bovine, Horse, Sheep, Rabbit, Dog, Chicken, Xenopus |
| Mol.Wt.: | 165kDa; 161kD(Calculated). |
| Uniprot: | O75116 |
| RRID: | AB_2835336 |
Product Info
*The optimal dilutions should be determined by the end user. For optimal experimental results, antibody reuse is not recommended.
*Tips:
WB: For western blot detection of denatured protein samples. IHC: For immunohistochemical detection of paraffin sections (IHC-p) or frozen sections (IHC-f) of tissue samples. IF/ICC: For immunofluorescence detection of cell samples. ELISA(peptide): For ELISA detection of antigenic peptide.
Cite Format: Affinity Biosciences Cat# AF3028, RRID:AB_2835336.
Fold/Unfold
coiled-coil-containing protein kinase 2; KIAA0619; p164 ROCK 2; p164 ROCK-2; Rho associated coiled coil containing protein kinase 2; Rho associated protein kinase 2; Rho associated, coiled coil containing protein kinase II; Rho kinase 2; Rho-associated; Rho-associated protein kinase 2; ROCK 2; Rock II; Rock2; ROCK2_HUMAN; Rock2m; ROK alpha; ROKalpha;
Immunogens
A synthesized peptide derived from human ROCK2 around the phosphorylation site of Tyr722.
- O75116 ROCK2_HUMAN:
- Protein BLAST With
- NCBI/
- ExPASy/
- Uniprot
MSRPPPTGKMPGAPETAPGDGAGASRQRKLEALIRDPRSPINVESLLDGLNSLVLDLDFPALRKNKNIDNFLNRYEKIVKKIRGLQMKAEDYDVVKVIGRGAFGEVQLVRHKASQKVYAMKLLSKFEMIKRSDSAFFWEERDIMAFANSPWVVQLFYAFQDDRYLYMVMEYMPGGDLVNLMSNYDVPEKWAKFYTAEVVLALDAIHSMGLIHRDVKPDNMLLDKHGHLKLADFGTCMKMDETGMVHCDTAVGTPDYISPEVLKSQGGDGFYGRECDWWSVGVFLYEMLVGDTPFYADSLVGTYSKIMDHKNSLCFPEDAEISKHAKNLICAFLTDREVRLGRNGVEEIRQHPFFKNDQWHWDNIRETAAPVVPELSSDIDSSNFDDIEDDKGDVETFPIPKAFVGNQLPFIGFTYYRENLLLSDSPSCRETDSIQSRKNEESQEIQKKLYTLEEHLSNEMQAKEELEQKCKSVNTRLEKTAKELEEEITLRKSVESALRQLEREKALLQHKNAEYQRKADHEADKKRNLENDVNSLKDQLEDLKKRNQNSQISTEKVNQLQRQLDETNALLRTESDTAARLRKTQAESSKQIQQLESNNRDLQDKNCLLETAKLKLEKEFINLQSALESERRDRTHGSEIINDLQGRICGLEEDLKNGKILLAKVELEKRQLQERFTDLEKEKSNMEIDMTYQLKVIQQSLEQEEAEHKATKARLADKNKIYESIEEAKSEAMKEMEKKLLEERTLKQKVENLLLEAEKRCSLLDCDLKQSQQKINELLKQKDVLNEDVRNLTLKIEQETQKRCLTQNDLKMQTQQVNTLKMSEKQLKQENNHLMEMKMNLEKQNAELRKERQDADGQMKELQDQLEAEQYFSTLYKTQVRELKEECEEKTKLGKELQQKKQELQDERDSLAAQLEITLTKADSEQLARSIAEEQYSDLEKEKIMKELEIKEMMARHKQELTEKDATIASLEETNRTLTSDVANLANEKEELNNKLKDVQEQLSRLKDEEISAAAIKAQFEKQLLTERTLKTQAVNKLAEIMNRKEPVKRGNDTDVRRKEKENRKLHMELKSEREKLTQQMIKYQKELNEMQAQIAEESQIRIELQMTLDSKDSDIEQLRSQLQALHIGLDSSSIGSGPGDAEADDGFPESRLEGWLSLPVRNNTKKFGWVKKYVIVSSKKILFYDSEQDKEQSNPYMVLDIDKLFHVRPVTQTDVYRADAKEIPRIFQILYANEGESKKEQEFPVEPVGEKSNYICHKGHEFIPTLYHFPTNCEACMKPLWHMFKPPPALECRRCHIKCHKDHMDKKEEIIAPCKVYYDISTAKNLLLLANSTEEQQKWVSRLVKKIPKKPPAPDPFARSSPRTSMKIQQNQSIRRPSRQLAPNKPS
Predictions
Score>80(red) has high confidence and is suggested to be used for WB detection. *The prediction model is mainly based on the alignment of immunogen sequences, the results are for reference only, not as the basis of quality assurance.
High(score>80) Medium(80>score>50) Low(score<50) No confidence
Research Backgrounds
Protein kinase which is a key regulator of actin cytoskeleton and cell polarity. Involved in regulation of smooth muscle contraction, actin cytoskeleton organization, stress fiber and focal adhesion formation, neurite retraction, cell adhesion and motility via phosphorylation of ADD1, BRCA2, CNN1, EZR, DPYSL2, EP300, MSN, MYL9/MLC2, NPM1, RDX, PPP1R12A and VIM. Phosphorylates SORL1 and IRF4. Acts as a negative regulator of VEGF-induced angiogenic endothelial cell activation. Positively regulates the activation of p42/MAPK1-p44/MAPK3 and of p90RSK/RPS6KA1 during myogenic differentiation. Plays an important role in the timely initiation of centrosome duplication. Inhibits keratinocyte terminal differentiation. May regulate closure of the eyelids and ventral body wall through organization of actomyosin bundles. Plays a critical role in the regulation of spine and synaptic properties in the hippocampus. Plays an important role in generating the circadian rhythm of the aortic myofilament Ca(2+) sensitivity and vascular contractility by modulating the myosin light chain phosphorylation.
Phosphorylation at Tyr-722 reduces its binding to RHOA and is crucial for focal adhesion dynamics. Dephosphorylation by PTPN11 stimulates its RHOA binding activity.
Cleaved by granzyme B during apoptosis. This leads to constitutive activation of the kinase and membrane blebbing.
Cytoplasm. Cell membrane>Peripheral membrane protein. Nucleus. Cytoplasm>Cytoskeleton>Microtubule organizing center>Centrosome.
Note: Cytoplasmic, and associated with actin microfilaments and the plasma membrane.
Expressed in the brain (at protein level).
An interaction between Thr-414 and Asp-48 is essential for kinase activity and dimerization.
Belongs to the protein kinase superfamily. AGC Ser/Thr protein kinase family.
Research Fields
· Cellular Processes > Cellular community - eukaryotes > Focal adhesion. (View pathway)
· Cellular Processes > Cellular community - eukaryotes > Tight junction. (View pathway)
· Cellular Processes > Cell motility > Regulation of actin cytoskeleton. (View pathway)
· Environmental Information Processing > Signal transduction > cGMP-PKG signaling pathway. (View pathway)
· Environmental Information Processing > Signal transduction > cAMP signaling pathway. (View pathway)
· Environmental Information Processing > Signal transduction > Sphingolipid signaling pathway. (View pathway)
· Environmental Information Processing > Signal transduction > Wnt signaling pathway. (View pathway)
· Human Diseases > Infectious diseases: Bacterial > Pathogenic Escherichia coli infection.
· Human Diseases > Infectious diseases: Bacterial > Shigellosis.
· Human Diseases > Infectious diseases: Bacterial > Salmonella infection.
· Human Diseases > Cancers: Overview > Pathways in cancer. (View pathway)
· Human Diseases > Cancers: Overview > Proteoglycans in cancer.
· Organismal Systems > Immune system > Chemokine signaling pathway. (View pathway)
· Organismal Systems > Circulatory system > Vascular smooth muscle contraction. (View pathway)
· Organismal Systems > Development > Axon guidance. (View pathway)
· Organismal Systems > Immune system > Platelet activation. (View pathway)
· Organismal Systems > Immune system > Leukocyte transendothelial migration. (View pathway)
· Organismal Systems > Endocrine system > Oxytocin signaling pathway.
References
Application: WB Species: human Sample:
Application: WB Species: bovine Sample: BMECs
Restrictive clause
Affinity Biosciences tests all products strictly. Citations are provided as a resource for additional applications that have not been validated by Affinity Biosciences. Please choose the appropriate format for each application and consult Materials and Methods sections for additional details about the use of any product in these publications.
For Research Use Only.
Not for use in diagnostic or therapeutic procedures. Not for resale. Not for distribution without written consent. Affinity Biosciences will not be held responsible for patent infringement or other violations that may occur with the use of our products. Affinity Biosciences, Affinity Biosciences Logo and all other trademarks are the property of Affinity Biosciences LTD.